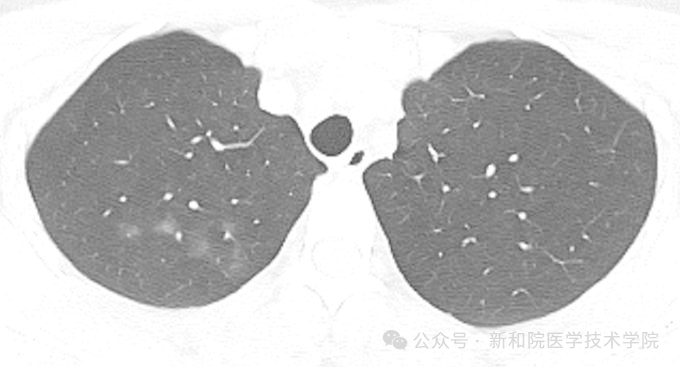
1E33E

体检季一到,不少人捧着肺部CT报告愁眉不展:“磨玻璃结节”、“钙化灶”、“条索影”……这些专业术语像天书,尤其是看到“结节”二字,瞬间联想到肺癌,整夜辗转难眠。
别慌!今天,资深影像科医生化身你的专属“肺部侦探”,用大白话为你三步解码报告。
无论你是面对报告焦虑不安的普通大众,还是刚刚踏入医学大门的医学生,这篇文章都能带你掌握看懂肺部的核心逻辑,告别不必要的焦虑,建立科学的认知。
CT报告上的术语,其实是医生描述肺部“痕迹”的专业暗号。对于大众,了解它们能去魅;对于医学生,理解这些征象背后的病理基础是入门第一课。
我们先来认识三位最常见的“嫌疑人”:
1号嫌疑人:【磨玻璃结节 (GGN)】—— 窗户上的薄雾
【侦探描述】 它在CT上看起来像块云雾状的淡薄影,就像窗户玻璃蒙了一层水雾,还能模模糊糊看到下方的血管轮廓。
【身份揭秘】 它是最让人纠结的“双面镜”。
良性可能: 可能是病毒性肺炎、肺水肿这类良性炎症留下的痕迹。
恶性可能: 也可能是原位腺癌等早期肿瘤的信号。
【关键对策】 别自己吓自己,关键是遵循医嘱,定期复查看变化。

2号嫌疑人:【钙化灶】—— 肺部的“疤痕勋章”
【侦探描述】 CT上的高密度亮点,白得发亮,密度和骨骼接近。
【身份揭秘】 这通常是肺部的一枚“良民证”。
90%以上是良性: 多是既往得过肺结核、肺炎,身体打赢了胜仗,愈合后钙盐沉积形成的“陈年旧疤”。
【关键对策】 基本无需特殊治疗,当成你战胜疾病的勋章就好。
3号嫌疑人:【条索影】—— 肺里的“天然皱纹”
【侦探描述】 呈现为线性僵直的高密度影,像一条条细线。
【身份揭秘】 它是肺部的“岁月痕迹”。
就像皮肤受伤后会留疤: 肺部经历过炎症、感染或损伤后,修复时就会形成这种纤维组织瘢痕。
【关键对策】 范围较小时对健康无影响,不用太在意。

认识了嫌疑人,接下来怎么判断它们是好是坏?这不仅是患者最关心的,也是影像专业学生必须掌握的基础诊断逻辑。
记住这套我们内部通用的“影像侦探实用口诀”,能帮你快速建立初步判断框架:
【⭐重要提醒(大众必读,学生必记)】这套口诀只是初步参考!临床情况复杂多变,每个人的病史、生活习惯(如吸烟史)、家族肿瘤史都不同。
最终诊断必须交给专业医生,结合进一步检查综合判断,切勿自行解读下结论!

每一份看似简单的肺部CT报告,背后都凝聚着影像医生的专业心血和多年积累。
我们就像在黑白世界里寻找蛛丝马迹的侦探,在无数张影像切片中,区分良性瘢痕与潜在风险,为你提供最准确的健康情报。
科学解读、理性应对,才是面对肺部CT报告的最佳姿态。如果对报告有疑问,别自己查资料瞎琢磨,及时咨询影像科或呼吸科医生,才是最稳妥的选择。

新疆和田学院医学技术学院带你走进影像医生的“侦探世界”!
如果你不仅想看懂自己的报告,更渴望系统地掌握人体的“黑白密码”,了解影像诊断底层的科学逻辑,欢迎来到我们学院!
这里有阅片实战技巧、专业术语拆解、病例分析复盘等专业课程。无论你是想成为未来的医学影像技术专家,还是对生命科学充满好奇,这里都是你探索医学奥秘的最佳起点。
欢迎有志于投身医学科技的你,加入我们,一同用影像之眼,守护生命健康!